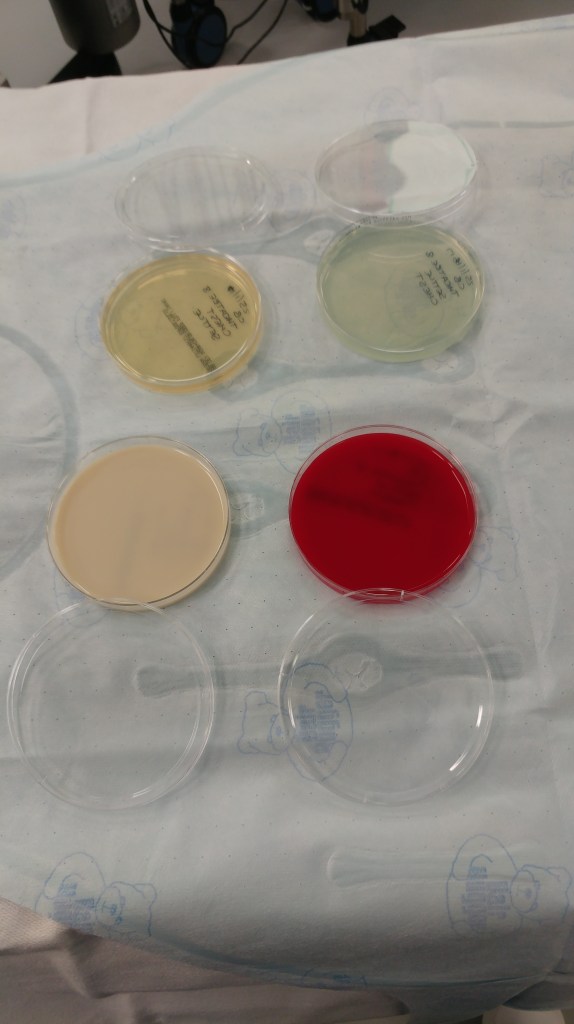

Due to the success of holding the event in Birmingham in 2018 the 2019 event stayed in the midlands. It focussed on ‘The role of ventilation in controlling airborne organisms
which play a role in healthcare associated infection’.
The structure of the day and the remit of the network was developed based on the results of a survey that was distributed through a variety of professional bodies and networks.
Meetings are structured with a number of lecture based sessions in the morning slot and case studies in the afternoon (see the case studies page for the case studies from all meetings).
The set up of the day focusses on shared learning and network development, so we can help support each other across the challenges that the environment can present.

Presentations from the day
Airborne pathogens: what are they and what kind of outbreaks
do they cause?
Dr John Hartley
Ventilation in healthcare settings: a user guide
Dr Peter Hoffman
Engineering aspects of ventilation control: how do we know
where the air goes?
Professor Catherine Noakes
Detecting airborne organisms: where we are and where we are
going to?
Dr Daniel McCluskey